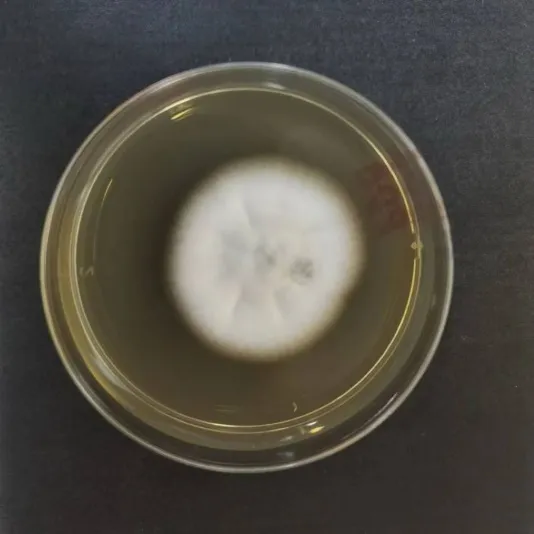

灰指甲,醫學上稱為甲真菌病,是由皮癬菌等真菌感染引起的常見疾病,導致指甲變色、增厚。它具有傳染性,中老年人、糖尿病患者等族群較易感。本文將詳細介紹其病因、防治方法以及幾個常見誤解。
一、灰指甲是病嗎?
灰甲,醫學上稱為甲真菌病(其中,由皮癬菌引起的甲真菌病,有時也稱為甲癬),其本質是指甲(趾甲)遭受病原真菌感染引起的一種疾病。灰甲並非由營養不良或遺傳缺陷直接引起。
雖然不同個體的易感性可能存在差異,但灰甲本質上是一種真菌感染性疾病。引起灰指甲最主要的病原體是皮癬菌(真菌),通常以紅色毛癬菌最常見(下圖)。此外,少數病例也可能由念珠菌屬或其他真菌引起。
灰甲的感染:通常始於甲板遠端邊緣(指尖方向)或甲板兩側與皮膚的交界處。
真菌首先侵入甲板下或甲板表層,利用角蛋白作為營養來源進行生長繁殖。
感染後,受侵指甲(趾甲)會出現典型的變化:
1.顏色異常:這是最直觀的表現,指甲可能失去正常光澤,變成渾濁的白色、黃色、褐色甚至灰黑色;
2.質地改變:甲板會明顯增厚、變得鬆脆易碎,表面變得粗糙、凹凸不平;
3.嚴重症狀:甲板與下方的甲床分離,形成空隙。隨著病情加重,患者可能會感到輕微疼痛,甚至影響行走。

二、哪些人容易得灰甲
灰甲作為一種傳染性疾病,在特定族群中發生率較高。例如,老年人由於免疫力自然下降、指甲生長變緩,更容易感染致病真菌;同樣地,患有糖尿病或免疫缺陷疾病的人群,也因其免疫力低下而面臨更高的感染風險。
某些生活習慣和身體狀態更容易誘發灰指甲(甲真菌病):
- 長期穿著密閉、透氣性差的鞋襪,或在公共場所(如公共浴室、游泳池)頻繁赤腳行走,會使得足部長期處於潮濕環境,這為真菌的滋生創造了有利條件。
- 足部多汗症患者的汗液增多,也為真菌提供了良好的營養基質,增加了感染風險。
- 過去患有足癬(俗稱「香港腳」)的人群需要特別注意,皮膚上的真菌可能會蔓延擴散到相鄰的指甲,導致灰指甲的發生。
三、得了灰甲,怎麼辦?
一旦確診灰指甲,應及時前往正規足病診療所就診。
醫師將明確致病真菌類型,以識別是否存在對常用抗真菌藥物耐藥的病原真菌,並根據感染的嚴重程度、範圍及潛在的耐藥情況制定個體化治療方案。
若感染較為嚴重或波及多個指甲,則需在醫師指導下治療。此外,激光治療等物理方法可作為輔助治療手段,具體根據足病診療師專業治理。
在整個治療過程中,務必保持指甲及周圍皮膚的清潔與乾燥,避免與他人共用指甲剪、毛巾、拖鞋等個人物品,以降低傳染給家人的風險。需要強調的是,不建議自行購買藥物或隨意中斷治療,否則容易導致治療失敗或復發。堅持規範治療是成功治癒灰甲的關鍵。

四、如何預防灰甲
灰指甲預防的核心在於減少接觸傳染源、破壞真菌滋生的有利環境、提升個人防護意識,包括:
1.保持足部清潔乾燥。建議每天認真清洗雙腳,特別是腳趾縫隙處,清洗後務必徹底擦乾。日常穿著吸濕性、透氣性良好、尺寸合適的鞋襪,並及時更換,以利於濕氣散發。在天氣炎熱或腳部出汗較多時,應增加更換鞋襪的頻率。
2.去往一些公共區域可以自備拖鞋。在公共浴池、游泳池、健身房更衣室、鋪設地毯的飯店等潮濕且人員密集場所,盡可能全程穿著自備或一次性的拖鞋行走,避免赤腳直接接觸地面。
3.個人衛生用品必須專人專用。切勿與他人混用指甲剪、銼刀、毛巾、浴巾、拖鞋、腳盆等可能直接或間接接觸足部的物品,家庭成員之間也應嚴格遵守。個人使用的指甲工具每次使用後最好先進行清潔消毒處理。
4.積極、及時治療足癬。足部皮膚上的病原真菌感染如果得不到有效控制,極易擴散蔓延至鄰近的趾甲。因此,一旦發現足癬症狀,應儘早醫進行規範治療,徹底清除皮膚上的真菌感染源。
5.特定族群需要增強防護意識。對於免疫力相對低的族群,如老年人、糖尿病患者或患有其他潛在疾病者,更需增強防護意識,嚴格遵循上述各項預防措施。同時,積極控制基礎疾病(如透過飲食、運動和藥物穩定血糖水平),既能維持身體免疫功能,也能減少為真菌提供有利的生長環境,從而降低感染風險。
預防灰甲是一項需要長期堅持的工作。一旦發現手指甲或腳趾甲出現顏色改變(如變白、變黃、變黑)、質地變厚、變脆、分離等異常情況,應及時前往正規醫療機構進行診斷。
早期發現和介入是成功治療和防止進一步傳播的關鍵。作為專業的足病診療所,我們的足病診療師擁有數25年臨床經驗,針對灰甲,憑藉多年經驗能準確判斷患者病況,對症下藥。
作為專業的足病診療所,我們的足病診療師擁有數25年臨床經驗,針對灰甲,憑藉多年經驗能準確判斷患者病況,對症下藥。提供全面灰甲治療療程,精準移除,不傷及周邊正常皮膚,傷口小、低痛感、恢復快。
五、灰指甲的常見誤區
迷思1:灰甲不治可以自癒——灰指甲是不能自癒的。
灰指甲由皮癬菌等病原真菌持續侵蝕甲板及甲床引起。導致灰指甲的真菌生命力頑強,可長期潛伏於甲組織內。
一旦感染發生,真菌會持續侵蝕指甲,病情通常不會自行好轉,反而可能逐漸加重,並可能導致指甲變形加重,甚至傳染給他人或身體其他部位(如皮膚)。
迷思2:和灰甲患者相處會傳染——直接相處傳播灰甲的風險極低。
皮癬菌等病原真菌主要透過接觸受污染的環境媒介傳播,如共用鞋襪、修甲工具、浴室地毯等。
但若雙方皮膚有破損,或接觸後未清洗即觸摸自身腳部,則有間接傳播可能。
日常社交無需過度恐慌,但需注重個人衛生,避免共用個人物品。
迷思3:灰甲都是灰色的——灰指甲不都是灰色的。
病甲顏色取決於感染菌種及病變階段。除灰黃色外,還可呈現白色(表淺白色型)、棕色、黑色(受產色素真菌影響)甚至綠色(合併細菌感染)。甲板增厚、渾濁、脆裂是更普遍的病徵。
迷思4:得了灰甲,一定要拔甲治療?——灰甲治療不一定要拔甲。
拔甲並非灰指甲的首選或常規治療方法,拔甲僅適用於甲板嚴重毀損、合併急性感染、或藥物無法滲透的頑固病例。單純拔甲並不能根治灰指甲,因為真菌可能存在於甲床、甲母質或周圍組織。
是否需要拔甲治療,需由醫師嚴格評估後決定。
迷思5:「偏方」可信嗎?——灰甲治療「偏方」不可信。
醋泡、蒜泥敷貼、不明中藥製劑等偏方,目前仍缺乏科學依據與嚴謹的臨床試驗驗證其安全性與有效性。
這些方法通常無法有效殺死深藏於甲板內部的真菌,延誤正規治療時機,甚至可能刺激皮膚引發接觸性皮膚炎、化學灼傷或繼發細菌感染,導致病情複雜。
因此,仍建議去正規足病診療所就診。
專業灰甲治療
所有灰甲的評估診斷及治療,均由澳洲註冊足病診療師親診,結合臨床積累的 25 年經驗,制定個性化治療方案,以低痛感、徹底根治為原則,解決指甲問題的同時,教會您日常護理方法,杜絕問題反覆。

關於灰甲治療,治療的重點在於足病診療師的手法,而非手術儀器;而能否根治,則是取決於個人的生活習慣。我們建議在決定做任何灰甲手術前,與我們了解,多一個意見,減少後遺症。
